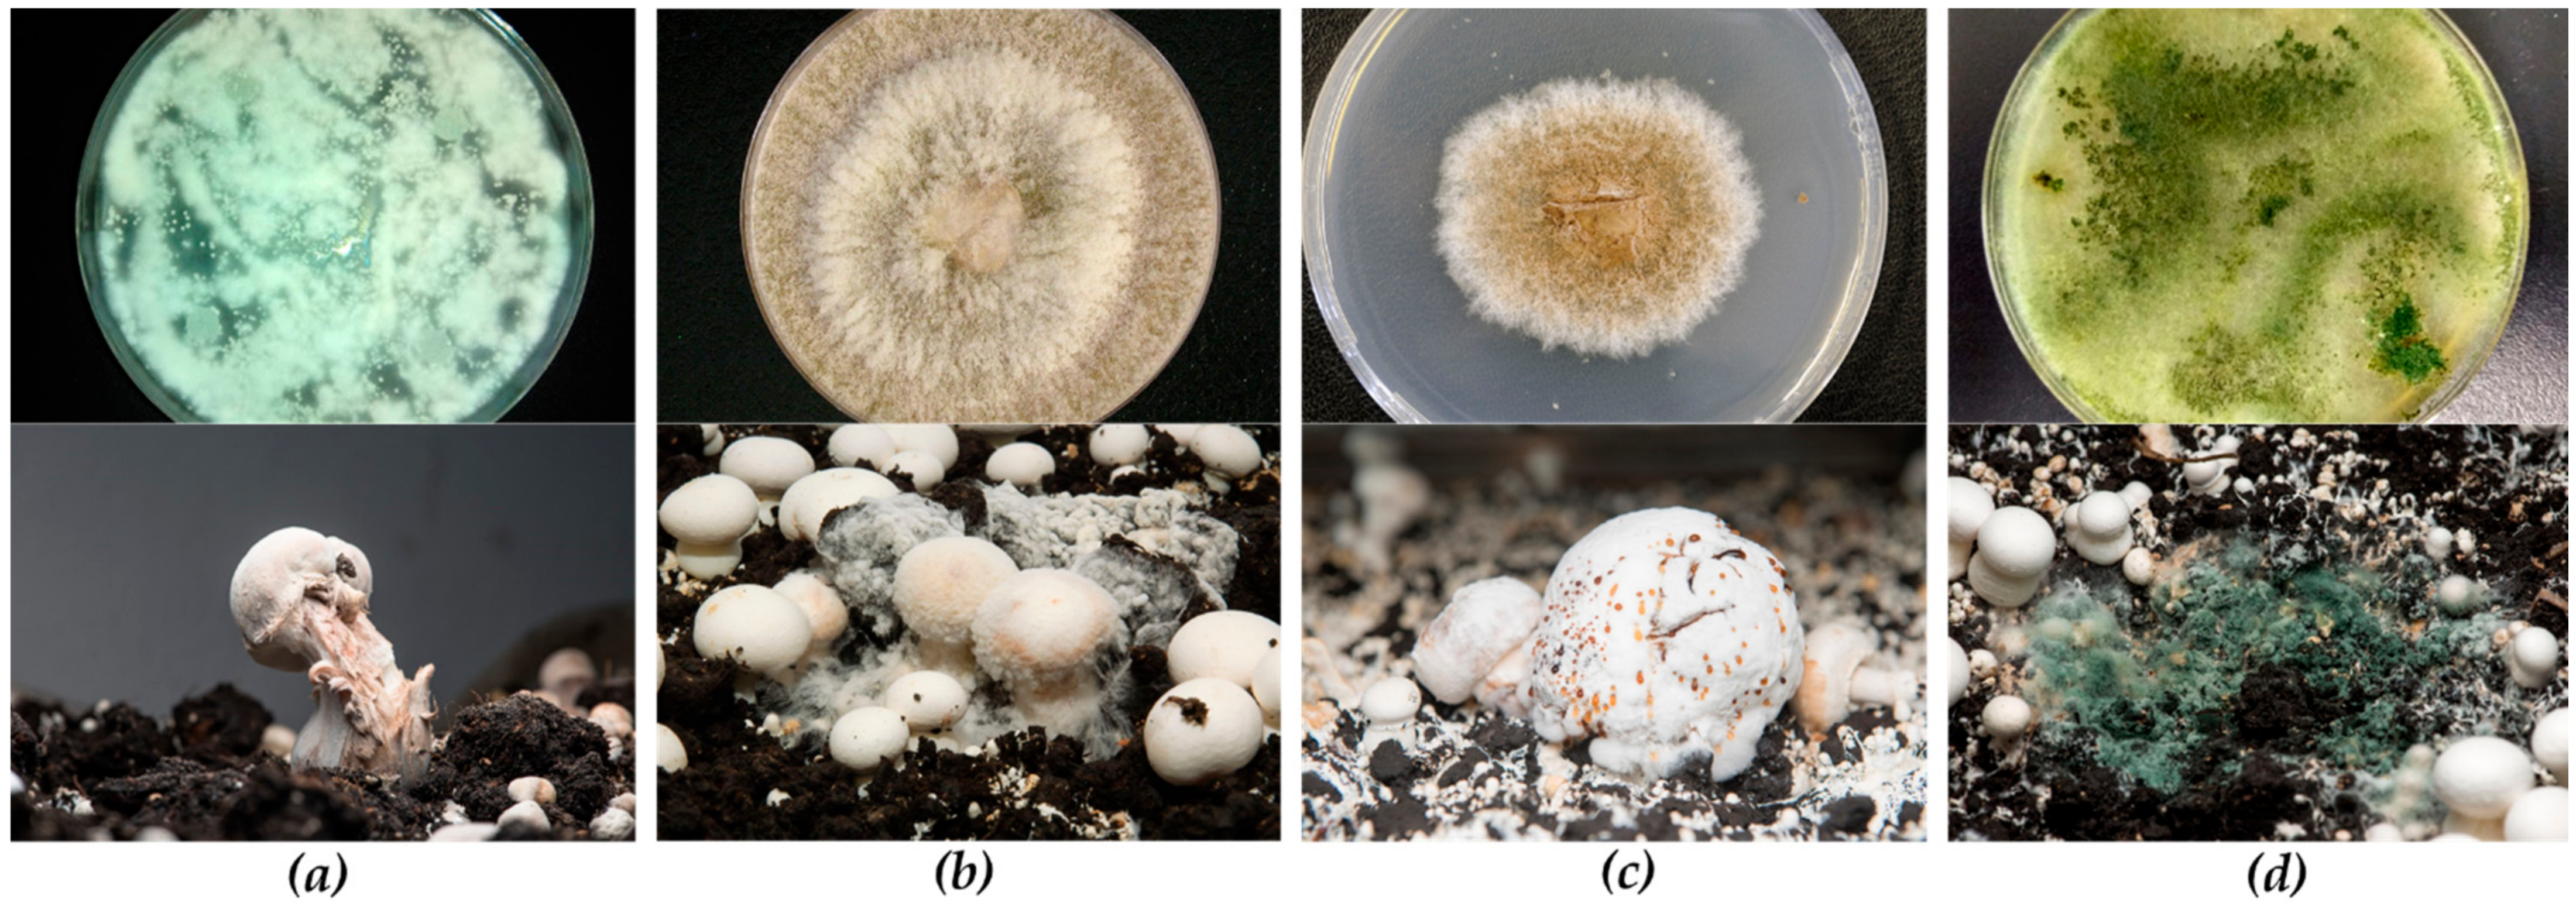

Control of Fungal Diseases in Mushroom Crops while Dealing with Fungicide Resistance: A Review
Abstract
1. Introduction
2. Dry Bubble (Lecanicillium fungicola)
2.1. Causative Agent and Symptoms of Disease
2.2. Chemical Control and Resistance
2.3. Alternative Control and Breeding
3. Cobweb Disease (Cladobotryum spp.)
3.1. Causative Agent and Symptoms of Disease
3.2. Chemical Control and Resistance
3.3. Alternative Control and Breeding
4. Wet Bubble (Mycogone Perniciosa)
4.1. Causative Agent and Symptoms of Disease
4.2. Chemical Control and Resistance
4.3. Alternative Control and Breeding
5. Green Mold (Trichoderma spp.)
5.1. Causative Agent and Symptoms of Disease
5.2. Chemical Control and Resistance
5.3. Alternative Control and Breeding
6. Recommended Hygienic Measures for the Control of Fungal Diseases
6.1. Hygienic Measures Common to the Four Diseases Described
6.2. Hygienic Measures Especially Recommended for the Control of Cobweb Disease
6.3. Hygienic Measures Especially Recommended for the Control of Green Mould Disease
7. Conclusions
Author Contributions
Funding
Institutional Review Board Statement
Informed Consent Statement
Data Availability Statement
Acknowledgments
Conflicts of Interest
References
- Royse, D.J.; Baars, J.; Tan, Q. Current Overview of Mushroom Production in the World. In Edible and Medicinal Mushrooms: Technology and Applications; Zied, D.C., Pardo-Gimenez, A., Eds.; John Wiley & Sons Ltd.: Chichester, UK, 2017; pp. 5–13. [Google Scholar]
- Fletcher, J.T.; Gaze, R.H. Mushroom Pest and Disease Control: A Colour Handbook, 1st ed.; Manson Publishing Ltd. Academic Press: San Diego, CA, USA, 2008; 192p. [Google Scholar]
- Gea, F.J.; Navarro, M.J. Mushroom Diseases and Control. In Edible and Medicinal Mushrooms: Technology and Applications; Zied, D.C., Pardo-Gimenez, A., Eds.; John Wiley & Sons Ltd.: Chichester, UK, 2017; pp. 239–259. [Google Scholar]
- Preston, G.M.; Carrasco, J.; Gea, F.J.; Navarro, M.J. Biological Control of Microbial Pathogens in Edible Mushrooms. In Biology of Macrofungi; Singh, B.P., Passari, A.K., Eds.; Springer: Cham, Switzerland, 2018; pp. 305–317. [Google Scholar]
- Largeteau, M.L.; Savoie, J.M. Microbially induced diseases of Agaricus bisporus: Biochemical mechanisms and impact on commercial mushroom production. Appl. Microbiol. Biotechnol. 2010, 86, 63–73. [Google Scholar] [CrossRef] [PubMed]
- Yoder, J.B.; Sinden, J.W.; Hauser, E. Experience with zinc ethylene bis-dithio-carbamate as a fungicide in mushroom cultivation. Mushr. Sci. 1950, 1, 100–108. [Google Scholar]
- Wuest, P.; Cole, H.; Sanders, P.L. Tolerance of Verticillium malthousei to benomyl. Phytopathology 1974, 64, 331–334. [Google Scholar] [CrossRef]
- Bollen, G.J.; van Zaayen, A. Resistance to benzimidazole fungicides in pathogenic strains of Verticillium fungicola. Neth. J. Plant Pathol. 1975, 81, 157–167. [Google Scholar] [CrossRef]
- Fletcher, J.T.; Yarham, D.J. The incidence of benomyl tolerance in Verticillium fungicola, Mycogone perniciosa and Hypomyces rosellus in mushroom crops. Ann. Appl. Biol. 1976, 84, 343–353. [Google Scholar] [CrossRef]
- Grogan, H.M.; Gaze, R.H. Fungicide resistance among Cladobotryum spp.—causal agents of cobweb disease of the edible mushroom Agaricus bisporus. Mycol. Res. 2000, 104, 357–364. [Google Scholar] [CrossRef]
- Grogan, H.M. Fungicide control of mushroom cobweb disease caused by Cladobotryum strains with different benzimidazole resistance profiles. Pest Manag. Sci. 2006, 2, 153–161. [Google Scholar] [CrossRef] [PubMed]
- Grogan, H.M.; Keeling, C.; Jukes, A.A. In vivo response of the mushroom pathogen Verticillium fungicola (dry bubble) to prochloraz-manganese. In Proceedings of the BCPC Conference: Pests and Diseases, Brighton, UK, 13–16 November 2000; British Crop Protection Council: Brighton, UK, 2000; pp. 273–278. [Google Scholar]
- Gea, F.J.; Navarro, M.J.; Tello, J.C. Reduced sensitivity of the mushroom pathogen Verticillium fungicola to prochloraz-manganese in vitro. Mycol. Res. 2005, 109, 741–745. [Google Scholar] [CrossRef] [PubMed]
- Pyck, N.; Sedeyn, P.; Demeulemeester, M.; Grogan, H. Evaluation of metrafenone against Verticillium and Cladobotryum spp.—Causal agents of dry bubble and cobweb disease. In Science and Cultivation of Edible and Medicinal Fungi–Mushroom Science XIX. Proceedings of the 19th International Congress on the Science and Cultivation of Edible and Medicinal Fungi; Baars, J.J.P., Sonnenberg, A.S.M., Eds.; Wageningen University and Research Centre: Amsterdam, The Netherlands, 2016; pp. 82–85. [Google Scholar]
- Carrasco, J.; Navarro, M.J.; Santos, M.; Gea, F.J. Effect of five fungicides with different modes of action on cobweb disease (Cladobotryum mycophilum) and mushroom yield. Ann. Appl. Biol. 2017, 171, 62–69. [Google Scholar] [CrossRef]
- Luković, J.; Milijašević-Marčić, S.; Hatvani, L.; Kredics, L.; Szűcs, A.; Vágvölgyi, C.; Duduk, N.; Vico, I.; Potočnik, I. Sensitivity of Trichoderma strains from edible mushrooms to the fungicides prochloraz and metrafenone. J. Environ. Sci. Health B 2020, 56, 54–63. [Google Scholar] [CrossRef]
- Van Zaayen, A.; Van Adrichem, J.C.J. Prochloraz for control of fungal pathogens of cultivated mushrooms. Neth. J. Plant Pathol. 1982, 88, 203–213. [Google Scholar] [CrossRef]
- Diamantopoulou, P.; Philippoussis, A.; Kastanias, M.; Flouri, F.; Chrysayi-Tokousbalides, M. Effect of famoxadone, tebuconazole and trifloxystrobin on Agaricus bisporus productivity and quality. Sci. Hortic. 2006, 109, 190–195. [Google Scholar] [CrossRef]
- Chrysayi-Tokousbalides, M.; Kastanias, M.A.; Philippoussis, A.; Diamantopoulou, P. Selective fungitoxicity of famoxadone, tebuconazole and trifloxystrobin between Verticillium fungicola and Agaricus bisporus. Crop Prot. 2007, 26, 469–475. [Google Scholar] [CrossRef]
- Sjaarda, C.P.; Abubaker, K.S.; Castle, A.J. Induction of lcc2 expression and activity by Agaricus bisporus provides defence against Trichoderma aggressivum toxic extracts. Microb. Biotechnol. 2015, 8, 918–929. [Google Scholar] [CrossRef]
- Sonnenberg, A.S.; Baars, J.J.P.; Gao, W.; Visser, R.G. Developments in breeding of Agaricus bisporus var. bisporus: Progress made and technical and legal hurdles to take. Appl. Microbiol. Biotechnol. 2017, 101, 1819–1829. [Google Scholar] [CrossRef] [PubMed]
- Morin, E.; Kohler, A.; Baker, A.R.; Foulongne-Oriol, M.; Lombard, V.; Nagye, L.G.; Martin, F. Genome sequence of the button mushroom Agaricus bisporus reveals mechanisms governing adaptation to a humic-rich ecological niche. Proc. Natl. Acad. Sci. USA 2012, 109, 17501–17506. [Google Scholar] [CrossRef] [PubMed]
- Banks, A.M.; Aminuddin, F.; Williams, K.; Batstone, T.; Barker, G.L.; Foster, G.D.; Bailey, A.M. Genome sequence of Lecanicillium fungicola 150-1, the causal agent of dry bubble disease. Microbiol. Resour. Announc. 2019, 8, 19. [Google Scholar] [CrossRef] [PubMed]
- Li, D.; Sossah, F.L.; Sun, L.; Fu, Y.; Li, Y. Genome analysis of Hypomyces perniciosus, the causal agent of wet bubble disease of button mushroom (Agaricus bisporus). Genes 2019, 10, 417. [Google Scholar] [CrossRef]
- Sossah, F.L.; Liu, Z.; Yang, C.; Okorley, B.A.; Sun, L.; Fu, Y.; Li, Y. Genome sequencing of Cladobotryum protrusum provides insights into the evolution and pathogenic mechanisms of the cobweb disease pathogen on cultivated mushroom. Genes 2019, 10, 124. [Google Scholar] [CrossRef] [PubMed]
- Xu, R.; Liu, X.; Peng, B.; Liu, P.; Li, Z.; Dai, Y.; Xiao, S. Genomic features of Cladobotryum dendroides, which causes cobweb disease in edible mushrooms, and identification of genes related to pathogenicity and mycoparasitism. Pathogens 2020, 9, 232. [Google Scholar] [CrossRef] [PubMed]
- Foulongne-Oriol, M.; Minvielle, N.; Savoie, J.M. QTL for resistance to Trichoderma lytic enzymes and metabolites in Agaricus bisporus. In Proceedings of the 7th International Conference on Mushroom Biology and Mushroom Products, Arcachon, France, 4–7 October 2011; Savoie, J.M., Foulougne-Oriol, M., Largeteau, M., Barroso, G., Eds.; INRA: Bordeaux, France, 2011; pp. 190–195. [Google Scholar]
- Fu, Y.; Wang, X.; Li, D.; Liu, Y.; Song, B.; Zhang, C.; Wang, Q.; Chen, M.; Zhang, Z.; Li, Y. Identification of resistance to wet bubble disease and genetic diversity in wild and cultivated strains of Agaricus bisporus. Int. J. Mol. Sci. 2016, 17, 1568. [Google Scholar] [CrossRef] [PubMed]
- Berendsen, R.L.; Baars, J.J.; Kalkhove, S.I.; Lugones, L.G.; Wösten, H.A.; Bakker, P.A. Lecanicillium fungicola: Causal agent of dry bubble disease in white-button mushroom. Mol. Plant Pathol. 2010, 11, 585–595. [Google Scholar] [CrossRef] [PubMed]
- Zare, R.; Gams, W. A revision of the Verticillium fungicola species complex and its affinity with the genus Lecanicillium. Mycol. Res. 2008, 112, 811–824. [Google Scholar] [CrossRef] [PubMed]
- Mehrparvar, M.; Mohammadi Goltapeh, E.; Safaei, N. Resistance of Iranian Lecanicillium fungicola to benzimidazole and ergosterol demethylation inhibiting fungicides. J. Agric. Sci. Technol. 2013, 15, 389–396. [Google Scholar]
- Carrasco, J.; Tello, M.L.; de Toro, M.; Tkacz, A.; Poole, P.; Pérez-Clavijo, M.; Preston, G. Casing microbiome dynamics during button mushroom cultivation: Implications for dry and wet bubble diseases. Microbiology 2019, 165, 611–624. [Google Scholar] [CrossRef] [PubMed]
- Caitano, C.E.; Iossi, M.R.; Pardo-Giménez, A.; Júnior, W.G.V.; Dias, E.S.; Zied, D.C. Design of a useful diagrammatic scale for the quantification of Lecanicillium fungicola disease in Agaricus bisporus cultivation. Curr. Microbiol. 2020, 77, 4037–4044. [Google Scholar] [CrossRef] [PubMed]
- Thao, L.D.; Binh, V.T.P.; Khanh, T.N.; Thanh, H.M.; Hien, L.T.; Anh, P.T.; Trang, T.T.T.; Dung, N.V.; Hoai, H.T. First report of Lecanicillium fungicola var. aleophilum infecting white-button mushroom in Vietnam. New Dis. Rep. 2020, 41, 23. [Google Scholar] [CrossRef]
- Marlowe, A.; Romaine, C.P. Dry bubble of oyster mushroom caused by Verticillium fungicola. Plant Dis. 1982, 66, 859–860. [Google Scholar] [CrossRef]
- Gea, F.J.; Tello, J.C.; Navarro, M.J. Occurrence of Verticillium fungicola var. fungicola on Agaricus bitorquis mushroom crops in Spain. J. Phytopathol. 2003, 151, 98–100. [Google Scholar] [CrossRef]
- Tasmanian Institute of Agriculture. Defending the Mushroom Industry against Disease. Available online: https://www.utas.edu.au/tia/news-events/news-items/defending-the-mushroom-industry-against-disease (accessed on 23 February 2021).
- Gomez, A. New technology in Agaricus bisporus cultivation. In Edible and Medicinal Mushrooms: Technology and Applications; Zied, D.C., Pardo-Gimenez, A., Eds.; John Wiley & Sons Ltd.: Chichester, UK, 2017; pp. 211–220. [Google Scholar]
- Piasecka, J.; Kavanagh, K.; Grogan, H. Detection of sources of Lecanicillium (Verticillium) fungicola on mushroom farms. In Proceedings of the 7th International Conference on Mushroom Biology and Mushroom Products, Arcachon, France, 4–7 October 2011; Savoie, J.M., Foulougne-Oriol, M., Largeteau, M., Barroso, G., Eds.; INRA: Bordeaux, France, 2011; pp. 479–484. [Google Scholar]
- Wong, W.C.; Preece, T.F. Sources of Verticillium fungicola on a commercial mushroom farm in England. Plant Pathol. 1987, 36, 577–582. [Google Scholar] [CrossRef]
- Bollen, G.J.; Fuchs, A. On the specificity of the in vitro and in vivo antifungal activity of benomyl. Neth. J. Plant Pathol. 1970, 76, 299–312. [Google Scholar] [CrossRef]
- Edgington, L.V.; Khew, K.I.; Barron, G.L. Fungitoxic spectrums of benzimidazole compounds. Phytopathology 1971, 61, 42–44. [Google Scholar] [CrossRef]
- Snel, M.; Fletcher, J.T. Benomyl and thiabendazole for the control of mushroom diseases. Plant Dis. Rep. 1971, 55, 120–121. [Google Scholar]
- Bonnen, A.M.; Hopkins, C. Fungicide resistance and population variation in Verticillium fungicola, a pathogen of the button mushroom, Agaricus bisporus. Mycol. Res. 1997, 101, 89–96. [Google Scholar] [CrossRef]
- Potočnik, I.; Vukojević, J.; Stajić, M.; Tanović, B.; Todorović, B. Fungicide sensitivity of selected Verticillium fungicola isolates from Agaricus bisporus farms. Arch. Biol. Sci. 2008, 60, 151–157. [Google Scholar] [CrossRef]
- Gea, F.J.; Tello, J.C.; Honrubia, M. In vitro sensitivity of Verticillium fungicola to selected fungicides. Mycopathologia 1996, 136, 133–137. [Google Scholar] [CrossRef] [PubMed]
- Fletcher, J.T.; Hims, M.J.; Hall, R.J. The control of bubble diseases and cobweb disease of mushrooms with prochloraz. Plant Pathol. 1983, 32, 123–131. [Google Scholar] [CrossRef]
- Carrasco, J.; Preston, G.M. Growing edible mushrooms: A conversation between bacteria and fungi. Environ. Microbiol. 2020, 22, 858–872. [Google Scholar] [CrossRef]
- Dianez, F.; Santos, M.; Boix, A.; de Cara, M.; Trillas, I.; Avilés, M.; Tello, J.C. Grape marc compost tea suppressiveness to plant pathogenic fungi: Role of siderophores. Compost Sci. Util. 2006, 14, 48–53. [Google Scholar] [CrossRef]
- Soković, M.; van Griensven, L.J.L.D. Antimicrobial activity of essential oils and their components against the three major pathogens of the cultivated button mushroom, Agaricus bisporus. Eur. J. Plant Pathol. 2006, 116, 211–224. [Google Scholar] [CrossRef]
- Tanović, B.; Potočnik, I.; Delibašic, G.; Ristić, M.; Kostić, M.; Marković, M. In vitro effect of essential oils from aromatic and medicinal plants on mushroom pathogens: Verticillium fungicola var. fungicola, Mycogone perniciosa, and Cladobotryum sp. Arch. Biol. Sci. 2009, 61, 231–237. [Google Scholar] [CrossRef]
- Gea, F.J.; Navarro, M.J.; Tello, J.C. Potential application of compost teas of agricultural wastes in the control of the mushroom pathogen Verticillium fungicola. J. Plant Dis. Prot. 2009, 116, 271–273. [Google Scholar] [CrossRef]
- Marín, F.; Santos, M.; Diánez, F.; Carretero, F.; Gea, F.J.; Yau, J.A.; Navarro, M.J. Characters of compost teas from different sources and their suppressive effect on fungal phytopathogens. World J. Microbiol. Biotechnol. 2013, 29, 1371–1382. [Google Scholar] [CrossRef] [PubMed]
- Gea, F.J.; Carrasco, J.; Diánez, F.; Santos, M.; Navarro, M.J. Control of dry bubble disease (Lecanicillium fungicola) in button mushroom (Agaricus bisporus) by spent mushroom substrate tea. Eur. J. Plant Pathol. 2014, 138, 711–720. [Google Scholar] [CrossRef]
- Mehrparvar, M.; Goltapeh, E.M.; Safaie, N.; Ashkani, S.; Hedesh, R.M. Antifungal activity of essential oils against mycelia growth of Lecanicillium fungicola var. fungicola and Agaricus bisporus. Ind. Crop. Prod. 2016, 84, 391–398. [Google Scholar] [CrossRef]
- Dos Santos, T.L.; Belan, L.L.; Zied, D.C.; Dias, E.S.; Alves, E. Essential oils in the control of dry bubble disease in white button mushroom. Cienc. Rural 2017, 47, e20160780. [Google Scholar] [CrossRef]
- Luković, J.; Stepanović, M.; Todorović, B.; Milijašević-Marčić, S.; Duduk, N.; Vico, I.; Potočnik, I. Antifungal activity of cinnamon and clove essential oils against button mushroom pathogens Cladobotryum dendroides (Bull.) W. Gams & Hooz. and Lecanicillium fungicola var. fungicola (Preuss) Hasebrauk. Pestic. Phytomed. 2018, 33, 19–26. [Google Scholar]
- Potočnik, I.; Vukojević, J.; Stajić, M.; Rekanović, E.; Stepanović, M.; Milijašević, S.; Todorović, B. Toxicity of biofungicide Timorex 66 EC to Cladobotryum dendroides and Agaricus bisporus. Crop Prot. 2010, 29, 290–294. [Google Scholar] [CrossRef]
- Dianez, F.; Santos, M.; Parra, C.; Navarro, M.J.; Blanco, R.; Gea, F.J. Screening of antifungal activity of twelve essential oils against eight pathogenic fungi of vegetables and mushroom. Lett. Appl. Microbiol. 2018, 67, 400–410. [Google Scholar] [CrossRef] [PubMed]
- Muhammad, I.; Sossah, F.L.; Yang, Y.; Li, D.; Li, S.; Fu, Y.; Li, Y. Identification of resistance to cobweb disease caused by Cladobotryum mycophilum in wild and cultivated strains of Agaricus bisporus and screening for bioactive botanicals. RSC Adv. 2019, 9, 14758–14765. [Google Scholar] [CrossRef]
- Gea, F.J.; Navarro, M.J.; Santos, M.; Diánez, F.; Herraiz-Peñalver, D. Screening and evaluation of essential oils from mediterranean aromatic plants against the mushroom cobweb disease, Cladobotryum mycophilum. Agronomy 2019, 9, 656. [Google Scholar] [CrossRef]
- Glamočlija, J.; Soković, M.; Vukojević, J.; Milenković, I.; Van Griensven, L.J.L.D. Chemical composition and antifungal activities of essential oils of Satureja thymbra L. and Salvia pomifera ssp. calycina (Sm.) Hayek. J. Essent. Oil Res. 2006, 18, 115–117. [Google Scholar] [CrossRef]
- Glamočlija, J.; Soković, M.; Grubisic, D.; Vukojevic, J.; Milinekovic, I.; Ristic, M. Antifungal activity of Critmum maritimum essential oil and its components against mushroom pathogen Mycogone perniciosa. Chem. Nat. Compd. 2009, 45, 96–97. [Google Scholar] [CrossRef]
- Potočnik, I.; Vukojević, J.; Stajic, M.; Tanovic, B.; Rekanovic, E. Sensitivity of Mycogone perniciosa, pathogen of culinary-medicinal button mushroom Agaricus bisporus (J. Lge) Imbach (Agaricomycetideae), to selected fungicides and essential oils. Int. J. Med. Mushrooms 2010, 12, 91–98. [Google Scholar] [CrossRef]
- Regnier, T.; Combrinck, S. In vitro and in vivo screening of essential oils for the control of wet bubble disease of Agaricus bisporus. S. Afr. J. Bot. 2010, 76, 681–685. [Google Scholar] [CrossRef]
- Sabharwal, A.; Kapoor, S. In vitro effect of essential oils on mushroom pathogen Mycogone perniciosa causal agent of wet bubble disease of white button mushroom. Indian J. Appl. Res. 2014, 4, 482–484. [Google Scholar] [CrossRef]
- Shokouhi, D.; Seifi, A. Organic extracts of seeds of Iranian Moringa peregrina as promising selective biofungicide to control Mycogone perniciosa. Biocatal. Agric. Biotechnol. 2020, 30, 101848. [Google Scholar] [CrossRef]
- Glamočlija, J.; Soković, M.; Tešević, V.; Linde, G.A.; Barros Colauto, N. Chemical characterization of Lippia alba essential oil: An alternative to control green molds. Braz. J. Microbiol. 2011, 42, 1537–1546. [Google Scholar] [CrossRef] [PubMed]
- Kosanović, D.; Potočnik, I.; Duduk, B.; Vukojević, J.; Stajić, M.; Rekanović, E.; Milijašević-Marčić, S. Trichoderma species on Agaricus bisporus farms in Serbia and their biocontrol. Ann. Appl. Biol. 2013, 163, 218–230. [Google Scholar] [CrossRef]
- Kong, R.; Wang, J.; Cheng, M.; Lu, W.; Chen, M.; Zhang, R.; Wang, X. Development and characterization of corn starch/PVA active films incorporated with carvacrol nanoemulsions. Int. J. Biol. Macromol. 2020, 164, 1631–1639. [Google Scholar] [CrossRef]
- Tanhaeian, A.; Nazifi, N.; Ahmadi, F.S.; Akhlaghi, M. Comparative study of antimicrobial activity between some medicine plants and recombinant Lactoferrin peptide against some pathogens of cultivated button mushroom. Arch. Microbiol. 2020, 202, 2525–2532. [Google Scholar] [CrossRef]
- On, A.; Wong, F.; Ko, Q.; Tweddell, R.J.; Antoun, H.; Avis, T.J. Antifungal effects of compost tea microorganisms on tomato pathogens. Biol. Control 2015, 80, 63–69. [Google Scholar] [CrossRef]
- Dianez, F.; Marín, F.; Santos, M.; Gea, F.J.; Navarro, M.J.; Piñeiro, M.; González, J.M. Genetic analysis and in vitro enzymatic determination of bacterial community in compost teas from different sources. Compost. Sci. Util. 2018, 26, 256–270. [Google Scholar] [CrossRef]
- Riahi, H.; Hashemi, M.; Sharifi, K. The effect of spent mushroom compost on Lecanicillium fungicola in vivo and in vitro. Arch. Phytopathol. Plant Prot. 2012, 45, 2120–2131. [Google Scholar] [CrossRef]
- Gea, F.J.; Santos, M.; Diánez, F.; Tello, J.C.; Navarro, M.J. Effect of spent mushroom compost tea on mycelial growth and yield of button mushroom (Agaricus bisporus). World J. Microbiol. Biotechnol. 2012, 28, 2765–2769. [Google Scholar] [CrossRef]
- Geösel, A.; Szabó, A.; Akan, O.; Szarvas, J. Effect of essential oils on mycopathogens of Agaricus bisporus. In Proceedings of the 8th International Conference on Mushroom Biology and Mushroom Products (ICMBMP8), New Delhi, India, 19–22 November 2014; Solan, H.P., Ed.; ICAR-Directorate of Mushroom Research: Solan, India, 2014; pp. 530–535. [Google Scholar]
- Zied, D.C.; Nunes, J.S.; Nicolini, V.F.; Gimenez, A.P.; Rinker, D.L.; Dias, E.S. Tolerance to Lecanicillium fungicola and yield of Agaricus bisporus strains used in Brazil. Sci. Hort. 2015, 190, 117–122. [Google Scholar] [CrossRef]
- Bailey, A.M.; Collopy, P.D.; Thomas, D.J.; Sergeant, M.R.; Costa, A.M.; Barker, G.L.; Mills, P.R.; Challen, M.P.; Foster, G.D. Transcriptomic analysis of the interactions between Agaricus bisporus and Lecanicillium fungicola. Fungal Genet. Biol. 2013, 55, 67–76. [Google Scholar] [CrossRef]
- Kim, M.K.; Lee, Y.H.; Cho, K.M.; Lee, J.Y. First report of cobweb disease caused by Cladobotryum mycophilum on the edible mushroom Pleurotus eryngii in Korea. Plant Dis. 2012, 96, 1374. [Google Scholar] [CrossRef]
- Back, C.G.; Lee, C.Y.; Seo, G.S.; Jung, H.Y. Characterization of species of Cladobotryum which cause cobweb disease in edible mushrooms grown in Korea. Mycobiology 2012, 40, 189–194. [Google Scholar] [CrossRef]
- Lakkireddy, K.; Khonsuntia, W.; Kües, U. Mycoparasite Hypomyces odoratus infests Agaricus xanthodermus fruiting bodies in nature. AMB Express 2020, 10, 1–22. [Google Scholar] [CrossRef]
- Chakwiya, A.; Van der Linde, E.J.; Korsten, L. In vitro sensitivity testing of Cladobotryum mycophilum to carbendazim and prochloraz manganese. S. Afr. J. Sci. 2015, 111, 1–7. [Google Scholar] [CrossRef][Green Version]
- Chakwiya, A.; Van der Linde, E.J.; Chidamba, L.; Korsten, L. Diversity of Cladobotryum mycophilum isolates associated with cobweb disease of Agaricus bisporus in the south African mushroom industry. Eur. J. Plant Pathol. 2019, 154, 767–776. [Google Scholar] [CrossRef]
- Zuo, B.; Lu, B.H.; Liu, X.L.; Wang, Y.; Ma, G.L.; Gao, J. First report of Cladobotryum mycophilum causing cobweb on Ganoderma lucidum cultivated in Jilin province, China. Plant Dis. 2016, 100, 1239. [Google Scholar] [CrossRef]
- Gea, F.J.; Carrasco, J.; Suz, L.M.; Navarro, M.J. Characterization and pathogenicity of Cladobotryum mycophilum in Spanish Pleurotus eryngii mushroom crops and its sensitivity to fungicides. Eur. J. Plant Pathol. 2017, 147, 129–139. [Google Scholar] [CrossRef]
- Gea, F.J.; Navarro, M.J.; Suz, L.M. First report of cobweb disease caused by Cladobotryum dendroides on shiitake mushroom (Lentinula edodes) in Spain. Plant Dis. 2018, 102, 1030. [Google Scholar] [CrossRef]
- Gea, F.J.; Navarro, M.J.; Suz, L.M. Cobweb disease on oyster culinary-medicinal mushroom (Pleurotus ostreatus) caused by the mycoparasite Cladobotryum mycophilum. J. Plant Pathol. 2019, 101, 349–354. [Google Scholar] [CrossRef]
- Carrasco, J.; Navarro, M.J.; Gea, F.J. Cobweb, a serious pathology in mushroom crops: A review. Span. J. Agric. Res. 2017, 15, 19. [Google Scholar] [CrossRef]
- Adie, B.; Grogan, H.; Archer, S.; Mills, P. Temporal and spatial dispersal of Cladobotryum conidia in the controlled environment of a mushroom growing room. Appl. Environ. Microbiol. 2006, 72, 7212–7217. [Google Scholar] [CrossRef] [PubMed]
- Lane, C.R.; Cooke, R.C.; Burden, L.J. Ecophysiology of Dactylium dendroides—The causal agent of cobweb mould. In Science and Cultivation of Edible Fungi, Vol. 1. 14th International Congress on the Science and Cultivation of Edible Fungi; Elliott, T.J., Ed.; Balkema: London, UK, 1991; pp. 365–372. [Google Scholar]
- Carrasco, J.; Navarro, M.J.; Santos, M.; Diánez, F.; Gea, F.J. Incidence, identification and pathogenicity of Cladobotryum mycophilum, causal agent of cobweb disease on Agaricus bisporus mushroom crops in Spain. Ann. Appl. Biol. 2016, 268, 214–224. [Google Scholar] [CrossRef]
- Tamm, H.; Põldmaa, K. Diversity, host associations and phylogeography of temperate aurofusarin producing Hypomyces/Cladobotryum including causal agents of cobweb disease of cultivated mushrooms. Fungal Biol. 2013, 117, 348–367. [Google Scholar] [CrossRef]
- Peeters, J. Parasitic fungi—A recurring nightmare. Mushroom Bus. 2018, 10, 30–37. [Google Scholar]
- Commission Implementing Regulation (EU). Concerning the Non-Renewal of the Approval of the Active Substance Chlorothalonil in Accordance with Regulation (EC) No. 1107/2009 of the European Parliament and of the Council Concerning the Placing of Plant Protection Products on the Market, and Amending Commission Implementing Regulation (EU) No. 540/2011. Off. J. Eur. Union 2019, L114, 15–17. [Google Scholar]
- McKay, G.J.; Egan, D.; Morris, E.; Brown, A.E. Identification of benzimidazole resistance in Cladobotryum dendroides using a PCR-based method. Mycol. Res. 1998, 102, 671–676. [Google Scholar] [CrossRef]
- Potočnik, I.; Stepanović, M.; Rekanović, E.; Todorović, B.; Milijašević-Marčić, S. Disease control by chemical and biological fungicides in cultivated mushrooms: Button mushroom, oyster mushroom and shiitake. Pestic. Phytomed. 2015, 30, 201–208. [Google Scholar] [CrossRef]
- Deng, Y.; Zhang, Q.; Ming, R.; Lin, L.; Lin, X.; Lin, Y.; Li, X.; Xie, B.; Wen, Z. Analysis of the mitochondrial genome in Hypomyces aurantius reveals a novel twintron complex in fungi. Int. J. Mol. Sci. 2016, 17, 1049. [Google Scholar] [CrossRef]
- Chen, C.; Wang, J.; Fu, R.; Chen, X.; Chen, X.; Lu, D. The complete mitochondrial genome of Cladobotryum mycophilum (Hypocreales: Sordariomycetes). Mitochondrial DNA B 2020, 5, 2595–2596. [Google Scholar] [CrossRef] [PubMed]
- Pieterse, Z. Mycogone perniciosa, a Pathogen of Agaricus bisporus. Ph.D. Thesis, University of Pretoria, Pretoria, South Africa, November 2005; 104p. [Google Scholar]
- Gea, F.J.; Tello, J.C.; Navarro, M.J. Efficacy and effects on yield of different fungicides for control of wet bubble disease of mushroom caused by the mycoparasite Mycogone perniciosa. Crop Prot. 2010, 29, 1021–1025. [Google Scholar] [CrossRef]
- Kouser, S.; Shah, S. Isolation and identification of Mycogone perniciosa, causing wet bubble disease in Agaricus bisporus cultivation in Kashmir. Afr. J. Agric. Res. 2013, 8, 4804–4809. [Google Scholar]
- Zhang, C.L.; Xu, J.Z.; Kakishima, M.; Li, Y. First report of wet bubble disease caused by Hypomyces perniciosus on Pleurotus citrinopileatus in China. Plant Dis. 2017, 101, 1321. [Google Scholar] [CrossRef]
- Wang, W.; Li, X.; Chen, B.; Wang, S.; Li, C.; Wen, Z. Analysis of genetic diversity and development of SCAR Markers in a Mycogone perniciosa population. Curr. Microbiol. 2016, 73, 9–14. [Google Scholar] [CrossRef]
- Zhou, C.; Li, D.; Chen, L.; Li, Y. Genetic diversity analysis of Mycogone perniciosa causing wet bubble disease of Agaricus bisporus in china using SRAP. J. Phytopathol. 2016, 164, 271–275. [Google Scholar] [CrossRef]
- Li, D.; Sossah, F.L.; Yang, Y.; Liu, Z.; Dai, Y.; Song, B.; Li, Y. Genetic and pathogenic variability of Mycogone perniciosa isolates causing wet bubble disease on Agaricus bisporus in China. Pathogens 2019, 8, 179. [Google Scholar] [CrossRef] [PubMed]
- Shi, N.; Ruan, H.; Jie, Y.; Chen, F.; Du, Y. Sensitivity and efficacy of fungicides against wet bubble disease of Agaricus bisporus caused by Mycogone perniciosa. Eur. J. Plant Pathol. 2020, 157, 873–885. [Google Scholar] [CrossRef]
- Soković, M.D.; Glamočlija, J.M.; Ćirić, A.D. Natural products from plants and fungi as fungicides. In Fungicides: Showcases of Integrated Plant Disease Management from Around the World; Nita, M., Ed.; IntechOpen: London, UK, 2013; pp. 185–232. [Google Scholar]
- Kim, W.G.; Weon, H.Y.; Seok, S.J.; Lee, K.H. In vitro antagonistic characteristics of bacilli isolates against Trichoderma spp. and three species of mushrooms. Mycobiology 2008, 36, 266–269. [Google Scholar] [CrossRef]
- Kim, J.Y.; Kwon, H.W.; Tang, L.; Kim, S.H. Identification and characterization of Trichoderma citrinoviride isolated from mushroom fly-infested oak log beds used for shiitake cultivation. Plant Pathol. J. 2012, 28, 219. [Google Scholar] [CrossRef][Green Version]
- Kim, J.Y.; Kwon, H.W.; Yun, Y.H.; Kim, S.H. Identification and characterization of Trichoderma species damaging shiitake mushroom bed-logs infested by Camptomyia pest. J. Microbiol. Biotechnol. 2016, 26, 909–917. [Google Scholar] [CrossRef] [PubMed]
- Kumar, K.; Kumar, M.; Singh, J.K.; Goyal, S.P.; Singh, S. Management of the green mould of milky mushroom (Calocybe indica) by fungicides and botanicals. Int. J. Curr. Microbiol. Appl. Sci. 2017, 6, 4931–4936. [Google Scholar] [CrossRef]
- Innocenti, G.; Montanari, M.; Righini, H.; Roberti, R. Trichoderma species associated with green mould disease of Pleurotus ostreatus and their sensitivity to prochloraz. Plant Pathol. 2019, 68, 392–398. [Google Scholar] [CrossRef]
- Kosanovic, D.; Grogan, H.; Kavanagh, K. Exposure of Agaricus bisporus to Trichoderma aggressivum f. europaeum leads to growth inhibition and induction of an oxidative stress response. Fungal Biol. 2020, 124, 814–820. [Google Scholar] [CrossRef] [PubMed]
- Hatvani, L.; Kredics, L.; Allaga, H.; Manczinger, L.; Vágvölgyi, C.; Kuti, K.; Geösel, A. First report of Trichoderma aggressivum f. aggressivum green mold on Agaricus bisporus in Europe. Plant Dis. 2017, 101, 1052. [Google Scholar] [CrossRef]
- Mazin, M.; Harvey, R.; Andreadis, S.; Pecchia, J.; Cloonan, K.; Rajotte, E.G. Mushroom sciarid fly, Lycoriella ingenua (Diptera: Sciaridae) adults and larvae vector Mushroom Green Mold (Trichoderma aggressivum ft. aggressivum) spores. Appl. Entomol. Zool. 2019, 54, 369–376. [Google Scholar] [CrossRef]
- Aydoğdu, M.; Kurbetli, İ.; Kitapçı, A.; Sülü, G. Aggressiveness of green mould on cultivated mushroom (Agaricus bisporus) in Turkey. J. Plant Dis. Prot. 2020, 127, 695–708. [Google Scholar] [CrossRef]
- Samuels, G.J.; Dodd, S.L.; Gams, W.; Castlebury, L.A.; Petrini, O. Trichoderma species associated with the green mold epidemic of commercially grown Agaricus bisporus. Mycologia 2002, 94, 146–170. [Google Scholar] [CrossRef] [PubMed]
- Kosanovic, D.; Potocnik, I.; Vukojevic, J.; Stajic, M.; Rekanovic, E.; Stepanovic, M.; Todorovic, B. Fungicide sensitivity of Trichoderma spp. from Agaricus bisporus farms in Serbia. J. Environ. Sci. Health B 2015, 50, 607e613. [Google Scholar] [CrossRef]
- Potočnik, I.; Todorović, B.; Đurović-Pejčev, R.; Stepanović, M.; Rekanović, E.; Milijašević-Marčić, S. Antimicrobial activity of biochemical substances against pathogens of cultivated mushrooms in Serbia. Pestic. Phytomed. 2016, 31, 19–27. [Google Scholar] [CrossRef]
- Potočnik, I.; Rekanović, E.; Todorović, B.; Luković, J.; Paunović, D.; Stanojević, O.; Milijašević-Marčić, S. The effects of casing soil treatment with Bacillus subtilis Ch-13 biofungicide on green mould control and mushroom yield. Pestic. Phytomed. 2019, 34, 53–60. [Google Scholar] [CrossRef]
- Pandin, C.; Védie, R.; Rousseau, T.; Le Coq, D.; Aymerich, S.; Briandet, R. Dynamics of compost microbiota during the cultivation of Agaricus bisporus in the presence of Bacillus velezensis QST713 as biocontrol agent against Trichoderma aggressivum. Biol. Control 2018, 127, 39–54. [Google Scholar] [CrossRef]
- Pandin, C.; Le Coq, D.; Deschamps, J.; Védie, R.; Rousseau, T.; Aymerich, S.; Briandet, R. Complete genome sequence of Bacillus velezensis QST713: A biocontrol agent that protects Agaricus bisporus crops against the green mould disease. J. Biotechnol. 2018, 278, 10–19. [Google Scholar] [CrossRef]
- Carrasco, J.; García-Delgado, C.; Lavega, R.; Tello, M.L.; De Toro, M.; Barba-Vicente, V.; Rodríguez-Cruz, M.S.; Sánchez-Martín, M.J.; Pérez, M.; Preston, G.M. Holistic assessment of the microbiome dynamics in the substrates used for commercial champignon (Agaricus bisporus) cultivation. Microb. Biotechnol. 2020, 13, 1933–1947. [Google Scholar] [CrossRef]
- Vieira, F.R.; Pecchia, J.A.; Segato, F.; Polikarpov, I. Exploring oyster mushroom (Pleurotus ostreatus) substrate preparation by varying phase I composting time: Changes in bacterial communities and physicochemical composition of biomass impacting mushroom yields. J. Appl. Microbiol. 2019, 126, 931–944. [Google Scholar] [CrossRef]
- Berendsen, R.L.; Kalkhove, S.I.C.; Lugones, L.G.; Baars, J.J.P.; Wösten, H.A.B.; Bakker, P.A.H.M. Effects of fluorescent Pseudomonas spp. isolated from mushroom cultures on Lecanicillium fungicola. Biol. Control 2012, 63, 210–221. [Google Scholar] [CrossRef]
- Milijašević-Marčić, S.; Stepanović, M.; Todorović, B.; Duduk, B.; Stepanović, J.; Rekanović, E.; Potočnik, I. Biological control of green mould on Agaricus bisporus by a native Bacillus subtilis strain from mushroom compost. Eur. J. Plant Pathol. 2017, 148, 509–519. [Google Scholar] [CrossRef]
- Stanojević, O.; Milijašević-Marčić, S.; Potočnik, I.; Stepanović, M.; Dimkić, I.; Stanković, S.; Berić, T. Isolation and identification of Bacillus spp. from compost material, compost and mushroom casing soil active against Trichoderma spp. Arch. Biol. Sci. 2016, 68, 845–852. [Google Scholar] [CrossRef]
- Abubaker, K.S.; Sjaarda, C.; Castle, A.J. Regulation of three genes encoding cell-wall-degrading enzymes of Trichoderma aggressivum during interaction with Agaricus bisporus. Can. J. Microbiol. 2013, 59, 417–424. [Google Scholar] [CrossRef] [PubMed]
- Pyck, N.; Grogan, H. Fungal Diseases of Mushrooms and Their Control; Factsheet 04/15, MushTV Publications; AHDB: Warwickshire, UK, 2015; p. 6. [Google Scholar]
- Beyer, D.M. Weed and indicator molds. In Mushroom Integrated Pest. Management Handbook; The Pennsylvania State University: State College, PA, USA, 2002; pp. 61–74. [Google Scholar]
| Target Mycoparasite/Disease | Bio-Based Formulation | Biocontrol Activity | Proposed Mechanism | Reference |
|---|---|---|---|---|
| Lecanicillium fungicola/Dry Bubble Disease (DBD) | Three concentrations (5%, 10%, and 15%) filtered, microfiltered, and sterilized aerated compost teas (ACT) from grape marc compost. | Filtered and microfiltered ACT exhibited 100% inhibition of mycelium growth in vitro. | Compost excreted siderophores (due to the microorganisms present in grape marc compost) which were responsible for inhibiting the mycelium growth. | Dianez et al. [49] |
| Essential oils (EOs) of Matricaria chamommilla, Mentha piperita, M. spicata, Lavandula angustifolia, Ocimum basilicum, Thymus vulgaris, Origanum vulgare, Salvia officinalis, Citrus limon and C. aurantium. | Oils from oregano and thymus species, containing phenolic compounds (carvacrol and thymol) showed the best inhibitory activity against the L. fungicola in vitro. | Components of EOs are responsible for the inhibitory effect (linalyl acetate, linalool, limonene, α-pinene, β-pinene, 1,8-cineole, camphor, carvacrol, thymol, and menthol). | Soković and van Griensven [50] | |
| EOs from lavender, anise, chamomile, fennel, geranium, oregano, parsley, and sage. | Oregano and geranium oils showed the most toxic effect against the L. fungicola var. fungicola when exposed to the volatile phase. | Components of EOs are related to their toxicity, oregano oil had a high content of carvacrol and thymol, geranium oil main components were citranelol and geraniol. | Tanović et al. [51] | |
| Untreated, autoclaved, or microfiltered non-aerated compost teas (NCT) from different sources (spent mushroom substrate, olive oil husk + cotton gin trash composted and mixed with rice husk, grape marc compost, and cork compost) were assayed against three L. fungicola isolates. Compost:water ratios of 1:4 and1:8 (w/v) were used and extraction periods of 1, 7, and 14 days. | Untreated NCT obtained the same % of mycelium inhibition as prochloraz-Mn. Autoclaving or microfiltration lost the activity. A period of 1–7 days and 1:4 dilution is recommended. | Antifungal activity due to the action of the active microbiota in the CT. | Gea et al. [52] | |
| ACT and NCT were obtained from four different composts: spent mushroom substrate compost, grape marc compost, greenhouse horticultural crop residues compost, and vermicompost. | ACT and NCT filtrates suppressed the mycelial growth of the mycopathogen in vitro. Sterilization by autoclaving or microfiltration removed partially or totally the inhibitory effect. | The efficacy of ACT and NCT depends on the microbiota present in them. | Marin et al. [53] | |
| NCT and ACT from SMS (spent mushroom substrate), one with mineral soil and the other with peat. | NCT and ACT from SMS significantly inhibited (100 %) the in vitro mycelial growth of L. fungicola. Treatments with aerated compost teas from SMS including peat-based casing reduced DBD incidence by 34–73 % in two crop trials, compared to an inoculated control. | Antifungal activity due to the action of the active microbiota in the CT. | Gea et al. [54] | |
| EOs from Citrus limonum, Citrus aurantium, Zataria multiflora, Satureja hortensis, Mentha pulegium, Mentha piperita, Anethum graveolens, Foeniculum vulgare, Artemisia dracunculus, Artemisia sieberi and Pelargonium roseum. | The EOs of thyme (Z. multiflora) and savory (S. hortensis) showed to be the most effective one since they showed the highest antifungal activity against mycoparasite and the best selectivity index between pathogen and host. | High antifungal activity of EOs thyme and savory due to the presence of phenolic components such as thymol and carvacrol detected by gas chromatography. | Mehrparvar et al. [55] | |
| EOs from Melissa officinalis, Thymus vulgaris, Origanum vulgare, Eucalyptus globulus, Cinnamomum zeylanicum, and Syzygium aromaticum. | Cinnamon and clove oils (0.4%) and thyme oil (0.8%) were the most efficient to inhibit the growth of pathogenic mycelium and prevent conidia germination in vitro. Thyme oil was effective to prevent DBD when applied in post-infection at 0.8%. | The occurrence of the disease is higher when the oils are applied pre-infestation, due to the volatility of the oils. Oil treatments prevent pathogenic conidia germination when applied post-infection probably due to the presence of phenolic compounds in their composition. | Dos Santos et al. [56] | |
| Inhibitory and fungicidal activity of two EOs, cinnamon (Cinnamomum verum) and clove (Syzygium aromaticum) tested by microdilution, macrodilution fumigant, and macrodilution contact method. | Clove oil showed the strongest activity than cinnamon against, showing the lowest minimum inhibitory concentration (MIC) in vitro against L. fungicola. Macrodilution fumigant method showed stronger antifungal effect than contact method. | Antifungal activity could be related to the presence of phenolic compounds within the EOs tested, such as eugenol, dominant phenolic compound in clove oil with proved strong antimicrobial activity. | Luković et al. [57] | |
| Cladobotryum spp./Cobweb disease | EOs from lavender, anise, chamomile, fennel, geranium, oregano, parsley, and sage. | Oregano and geranium oils showed the most toxic effect against the Cladobotryum sp. when exposed to the volatile phase. | Components of EOs are related to their toxicity, oregano oil had high content of carvacrol and thymol, geranium oil main components were citranelol and geraniol. | Tanović et al. [51] |
| Biofungicide: tea tree oil (Timorex 66 EC), based on the EO of Melaleuca alternifolia. | Tea tree oil was less toxic than prochloraz–manganese in vitro against C. dendroides isolates. Tea tree oil (drench application at 1%) applied in infected trials caused a significant reduction in cobweb disease and was not toxic against the crop (A. bisporus). | Most components of tea tree oil (highest antifungal activity due to the components: terpinen-4-ol, α-terpineol, linalool, α-pinene, and β-pinene) have activity against a range of fungi. | Potočnik et al. [58] | |
| Inhibitory and fungicidal activity of two EOs, cinnamon (Cinnamomum verum) and clove (Syzygium aromaticum) tested by microdilution, macrodilution fumigant, and macrodilution contact method. | Clove oil showed the strongest activity than cinnamon, showing the lowest minimum inhibitory concentration (MIC) in vitro against C. dendroides. Macrodilution fumigant method showed a stronger antifungal effect than the contact method. | Antifungal activity could be related to the presence of phenolic compounds within the EOs tested, such as eugenol, dominant phenolic compound in clove oil with proved strong antimicrobial activity. | Luković et al. [57] | |
| EOs extracted from 12 botanicals: Syzygium aromaticum, Pelargonium graveolens, L. angustifolia, Cupresus sempervirens, M. piperita, Santolina chamaecyparissus, Citrus sinensis, Pogostemon patchouli, Thymus mastichina, Thymus vulgaris, Eucalyptus globulus, and R. officinalis. | EOs obtained from clove, peppermint, patchouli, and rose geranium showed high antifungal activity in vitro against C. mycophilum with very low ED50 levels of 1.6, 7.4, 0.6, and 0.3%, respectively. | GC-MS showed eugenol in clove (86.38%), L-Menthol (41.97%) in peppermint, patchouli alcohol (33.40%) in patchouli, and citronellol (31.51%) in rose geranium as main components of these fungitoxic EOs. | Dianez et al. [59] | |
| Aqueous extracts from seven dried botanicals: mint leaves and stem (Mentha longifolia), garlic bulb (Allium sativum), turmeric rhizome (Curcuma longa), ginger rhizome (Zingiber officinale), clove seeds/buds (Syzygium aromaticum), cinnamon seeds (Cinnamomum zeylanicum), and neem leaves (Azadirachta indica). | Syzygium aromaticum, exhibited the maximum inhibition (99.48%) in vitro against C. mycophilum in amended PDA. | The spectra corresponding to the bioactive chemical constituents in S. aromaticum using Fourier transform infrared (FTIR) spectroscopy showed maximum intensive peak at 3375 cm–1 that represents the OH groups, this peak could correspond to antifungal phenolic compounds. | Idrees et al. [60] | |
| EOs obtained by hydrodistillation from five aromatic plants (Lavandula × intermedia, Salvia lavandulifolia, Satureja montana, Thymus mastichina, and Thymus vulgaris). | T. vulgaris and S. montana (ED50 = 35.5 and 42.8 mg L−1, respectively) showed the highest toxicity in vitro for inhibiting the mycelial growth of C. mycophilum, and the best selectivity between the pathogen and A. bisporus. EO from T. vulgaris showed some efficacy at controlling cobweb disease when used at the 1% rate in artificially infected crop trials. | The antimicrobial compounds carvacrol (17.22%) for S. montana and thymol (25.78%) for T. vulgaris were the most abundant phenolic compounds of these EOs, that also content contained a significant proportion of the biological precursors of the phenolic components p-cymene. | Gea et al. [61] | |
| Mycogone perniciosa/Wet Bubble Disease (WBD) | EOs isolated from savory (Satureja thymbra) and sage (Salvia pomifera ssp. calycina). | S. thymbra EO showed better antifungal activity against M. perniciosa than S. pomifera oil in vitro by the microatmosphere method, minimal inhibitory quantity (MIQ), of 0.05 μL mL−1 and minimal fungicidal quantity (MFQ), of 0.25 μL mL−1. | The antifungal activity is related to the composition of the EOs as assessed by GC-MS: in S. thymbra, oils were γ-terpinene (23.2%) and carvacrol (48.5%), while in S. pomifera oil were α-thujone (20.4%) and β-thujone (36.1%). | Glamočlija et al. [62] |
| EO from Critmum maritimum extracted from fresh plant material. | The essential oil of C. maritimum possessed antifungal activity in vitro, with MIQ = 1 μL disc-1 and MFQ = 20 μL disc−1 against M. perniciosa. | The chemical composition of C. maritimum EOs related to antifungal activity. With the two most abundant components, α-pinene (26.29%) and limonene (31.74%) showing strong antifungal activity. | Glamočlija et al. [63] | |
| EOs from lavender, anise, chamomile, fennel, geranium, oregano, parsley, and sage. | Oregano and geranium oils showed the most toxic effect against the M. perniciosa when exposed to the volatile phase. | Components of EOs are related to their toxicity, oregano oil had a high content of carvacrol and thymol, geranium oil’s main components were citranelol and geraniol. | Tanović et al. [51] | |
| EOs from seven botanicals. | Thymus vulgaris oil possessed the highest antifungal activity in vitro against M. perniciosa by microatmosphere method, with MIQ and MFQ of 0.02 μL mL−1 of air. Pistacia terebinthus showed the lowest antifungal effect, MIQ and MFQ of 0.16 and 0.65 μL mL−1 of air. | Oils from thymus species contain phenolic compounds (carvacrol and thymol) showing proved antimicrobial activity. | Potočnik et al. [64] | |
| Forty EOs, seven pure terpenoids, and one phenylpropanoid. | Lemon verbena (Lippia citriodora), lemongrass (Cymbopogon citratus) and thyme (Thymus vulgaris) oils substantially inhibited the growth of M. perniciosa in vitro, with the best selectivity between pathogen and host. Lemon verbena or thyme oils was able to control the development of WBD in casing-infected trial with innocuous effect to the host. | The main components of these oils, nerol and thymol, determined by GC–FID and GC–MS, showed antifungal activity, selective to the pathogen M. perniciosa. | Regnier and Combrinck [65] | |
| EOs from clove, castor, eucalyptus, olive, citrullina, and cinnamic aldehyde | Cinnamon oil in the form of cinnamic aldehyde (2.5 and 5 μL L−1) and eucalyptus oil (2.5 and 7.5 μL L−1) were the most effective to inhibit M. perniciosa in vitro with non-detrimental effect to the host strain at these doses. | Antifungal activity probably related to the chemical composition of the EOs and extracts (mainly due to the presence of phenolic compounds). | Sabharwal and Kapoor [66] | |
| Organic extracts of seeds of Moringa peregrina. | Moringa seed extracts inhibited the growth of both M. perniciosa in lower concentration than A. bisporus, through in vitro tests. | Candidates for the antifungal components in the seeds can be fatty acids like oleic acid and palmitic acid. Secondary metabolites such as sothiocyanates (99.9% of the volatile components of Iranian Moringa seeds) are also candidates for antifungal activity. | Shokouhi and Seifi [67] | |
| Trichoderma spp./Green mold | Essential oils (EOs) of Matricaria chamommilla, Mentha piperita, M. spicata, Lavandula angusti folia, Ocimum basilicum, Thymus vulgaris, Origanum vulgare, Salvia officinalis, Citrus limon and C. aurantium. | Oils from oregano and thymus species, containing phenolic compounds (carvacrol and thymol) showed the best inhibitory activity against the T. harzianum in vitro. | Components of EOs are responsible for the inhibitory effect (linalyl acetate, linalool, limonene, α-pinene, β-pinene, 1,8-cineole, camphor, carvacrol, thymol, and menthol). | Soković and van Griensven [50] |
| EO was extracted from Lippia alba by Clevenger hydrodistillation. | L. alba EO presented antifungal activity, with MIC of 0.6 mg mL-1 and MFC of 1.250 mg mL-1, against Trichoderma viride. | Geranial identified by GC-MS and NMR was described to be the main fungicidal component of this EO (50.9% of the chemical composition of L. alba EO) | Glamočlija et al. [68] | |
| Biofungicide: Timorex Gold (BM 608) EC (Stockton-Agrimor, Petach Tikva, Israel) based on tea tree oil (tea tree oil 23.8%; solvent 65.4%; ethanol 4.0%; NaOH 2.3%, and surfactant 4.5%), based on the EO of Melaleuca alternifolia. | Tea tree oil did not exhibit significant antifungal activity in vitro (ED50 = 11.9–370.8 mg L−1) against T. atroviride, T. koningii, T. virens, T. aggressivum f. europaeum, and T. harzianum. The biofungicide based on B. subtilis demonstrated greater effectiveness in preventing disease symptoms than tea tree oil. However, when combined with prochloraz-Mn, tea tree oil showed higher antagonism. | Most components of tea tree oil (highest antifungal activity due to the components: terpinen-4-ol, α-terpineol, linalool, α-pinene, and β-pinene) have activity against a range of fungi. | Kosanović et al. [69] | |
| EOs extracted from 12 botanicals: Syzygium aromaticum, Pelargonium graveolens, L. angustifolia, Cupresus sempervirens, M. piperita, Santolina chamaecyparissus, Citrus sinensis, Pogostemon patchouli, Thymus mastichina, Thymus vulgaris, Eucalyptus globulus and R. officinalis. | Trichoderma aggressivum f.sp. europaeum was less sensitive than C. mycophilum to the same EOs tested in vitro. It was most inhibited by peppermint, patchouli, and rosemary EOs with ED50 levels of 12.7%, 11.7%, and 3.4% in the growth medium, respectively. | GC-MS showed L-Menthol (41.97%) in peppermint, patchouli alcohol (33.40%) in patchouli, and citronellol (31.51%) in rose geranium as main components of these fungitoxic EOs. | Dianez et al. [59] | |
| An active film prepared by corn starch, polyvinyl alcohol, and carvacrol nanoemulsions (CNE). | More than 10% CNE applied into the film formulation showed inhibition against Trichoderma sp. Films with 25% CNE exhibited excellent antifungal activity with an inhibitory zone of 47 mm. | Efficient antifungal phenolic compound carvacrol. | Kong et al. [70] | |
| Plants essential oils and plant extracts of six medicinal plants (Lippia citriodora, Ferula gummosa, Bunium persicum, Mentha piperita, Plantago major, and Salvadora persica). In addition to a chimera peptide of camel lactoferrin (antimicrobial component of camel milk). | L. citriodora, B. persicum, and M. piperita treatments could completely prevent the growth of T. harzianum under in vitro conditions through disc diffusion method. | Antifungal activity probably related to the chemical composition of the EOs and extracts (mainly due to the presence of phenolic compounds). | Tanhaeian et al. [71] |
| Strain/Disease | Genome (NCBI Acc. No) | Gene Prediction and Annotation | Lifestyle, Mycoparasitism, and Disease Resistance | Reference |
|---|---|---|---|---|
| Agaricus bisporus var. bisporus H97/Host | AEOK00000000 | Wide repertoire of HTP*, β-etherases, multicopper oxidase, and CYP450* oxidoreductases up-regulated in mycelium-colonizing compost. The large gene of compost-induced CAZymes and oxidoreductases, together with high protein degradation and nitrogen-scavenging abilities. | Genetic and enzymatic mechanisms governing adaptation of A. bisporus to the selective substrate employed in mushroom cultivation and the fructification in the casing layer. | Morin et al. [22] |
| Lecanicillium fungicola strain 150-1/DBD * | FWCC00000000 | 37 biosynthetic gene clusters for secondary metabolites including 8 PKSs*, 21 NRPS* or NRPS-like clusters, 3 PKS-NRPS hybrids, 5 terpene synthases, and 1 indole cluster. | Analysis of these gene clusters is ongoing and could provide insight into the mechanistic of fungus–fungus interactions. | Banks et al. [23] |
| Cladobotryum protrusum strain CCMJ2080/Cobweb | RZGP00000000 | The sequenced genome contained 412 CAZymes, 143 secondary metabolites, P450, and 1038 and 453 PHI (pathogen–host interaction) and DFVF* genes. | Arrays of genes that potentially produce bioactive secondary and stress response-related proteins could be associated with the mycoparasitic lifestyle. Long interspersed element (LINE) detected in the genome (0.60%) could be related to the occurrence of resistance to DMI such as the commonly used prochloraz-Mn. | Sossah et al. [25] |
| Cladobotryum dendroides strain CCMJ2807/Cobweb | WWCI01000000 | The sequenced genome contained 327 CAZymes, 116 secondary metabolites. The authors identified 336 (3.52%), 175 (1.83%), and 48 genes encoding for cytochrome P450, 175 major facilitator superfamily (MFS) transporters (Pfam domain assignment), and 48 ATP-binding cassette (ABC) transporters. | Pathogenicity-related genes were predicted in C. dendroides strongly associated with pathogenicity (such as CAZymes and fungal effectors), virulence (genes related to secondary metabolites production), and resistance. | Xu et al. [26] |
| Hypomyces perniciosus strain HP10/WBD* | SPDT00000000 | 336 CAZymes analysis of six classes, 91 secondary metabolites gene clusters including T1PKS), non-ribosomal peptide synthetase hybrids, terpene synthases, and NRPS, and pathogenicity-related Genes (including 399 proteases and 125 cytochrome P450 or hydrophobins). | Resource data generated identified genes characterized to explain the basis of the mycoparasitic lifestyle in H. perniciosus as causal agent of wet bubble disease. | Li et al. [24] |
Publisher’s Note: MDPI stays neutral with regard to jurisdictional claims in published maps and institutional affiliations. |
© 2021 by the authors. Licensee MDPI, Basel, Switzerland. This article is an open access article distributed under the terms and conditions of the Creative Commons Attribution (CC BY) license (http://creativecommons.org/licenses/by/4.0/).
Share and Cite
Gea, F.J.; Navarro, M.J.; Santos, M.; Diánez, F.; Carrasco, J. Control of Fungal Diseases in Mushroom Crops while Dealing with Fungicide Resistance: A Review. Microorganisms 2021, 9, 585. https://doi.org/10.3390/microorganisms9030585
Gea FJ, Navarro MJ, Santos M, Diánez F, Carrasco J. Control of Fungal Diseases in Mushroom Crops while Dealing with Fungicide Resistance: A Review. Microorganisms. 2021; 9(3):585. https://doi.org/10.3390/microorganisms9030585
Chicago/Turabian StyleGea, Francisco J., María J. Navarro, Milagrosa Santos, Fernando Diánez, and Jaime Carrasco. 2021. "Control of Fungal Diseases in Mushroom Crops while Dealing with Fungicide Resistance: A Review" Microorganisms 9, no. 3: 585. https://doi.org/10.3390/microorganisms9030585
APA StyleGea, F. J., Navarro, M. J., Santos, M., Diánez, F., & Carrasco, J. (2021). Control of Fungal Diseases in Mushroom Crops while Dealing with Fungicide Resistance: A Review. Microorganisms, 9(3), 585. https://doi.org/10.3390/microorganisms9030585

